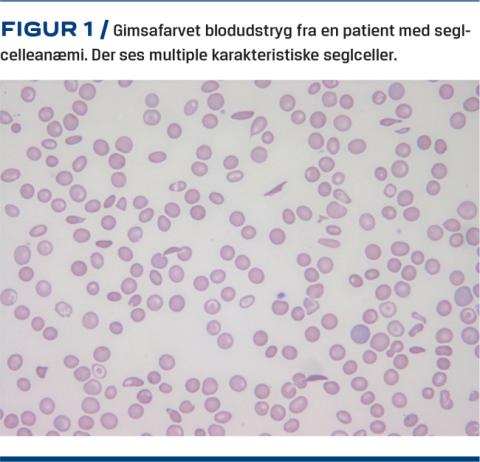

Seglcellesygdom (SCD) er den hyppigst forekommende alvorlige hereditære sygdom i verden. Hos kvinder kan SCD give alvorlige komplikationer i forbindelse med graviditet og fødsel. Tilstanden behandles på højtspecialiserede afdelinger, men alle læger kan møde gravide med SCD, hvorfor viden om behandling af disse patienter er vigtig. I denne artikel sætter vi fokus på ætiologi, udredning, svangreomsorg og behandling af gravide med SCD.
-
Seglcellesygdom er den hyppigste alvorlige, arvelige sygdom i verden.
-
Seglcellesygdom kan forværres i en graviditet og er associeret med komplikationer for både mor og barn.
-
Svangreomsorg og behandling skal ske i et tværfagligt samarbejde mellem en obstetriker med erfaring i højrisikograviditeter og en hæmatolog med erfaring inden for hæmoglobinopatier.
-
Seglcellesygdom er den hyppigste alvorlige, arvelige sygdom i verden.
-
Seglcellesygdom kan forværres i en graviditet og er associeret med komplikationer for både mor og barn.
-
Svangreomsorg og behandling skal ske i et tværfagligt samarbejde mellem en obstetriker med erfaring i højrisikograviditeter og en hæmatolog med erfaring inden for hæmoglobinopatier.
ÆTIOLOGI
SCD er en fællesbetegnelse for en gruppe autosomalt recessive sygdomme, som alle har en punktmutation i betaglobulinkædegenet (βS-genet). Dette medfører dannelsen af seglcellehæmoglobin (HbS) i stedet for hæmoglobin A1[1]. Den mest udbredte og alvorlige form for SCD forekommer hos personer, der er homozygote for HbS, og betegnes seglcelleanæmi (SCA). Desuden forekommer der en række compoundheterozygote tilstande, hvor HbS nedarves sammen med β-thalassæmi eller en anden hæmoglobinvariant, herunder HbS/β0-talassæmi, HbS/β+-talassæmi og HbSC-sygdom. Personer som er heterozygote for HbS betegnes som havende seglcelletræk. En tilstand, der i reglen ikke medfører kliniske komplikationer.
Patofysiologien ved SCD er en konsekvens af en intracellulær polymerisering af HbS, når dette deoxygeneres. Herved deformeres erytrocytten til den karakteristiske seglcelleform (Figur 1). Seglceller er rigide og kan ikke passere mikrocirkulationen. Cellerne har betydeligt kortere levetid end raske erytrocytter (ca. 20 dage), hvorfor personer med SCD har kronisk hæmolytisk anæmi. Derudover har seglcellerne tendens til at aggregere med hinanden, hvilket fører til mikrocirkulatoriske problemer med vasookklusion i de små blodkar og hypoksi til følge. Desuden ses der en øget adhæsion af seglcellerne til endotelet, hvilket yderligere reducerer gennemblødningen og kan føre til makrovaskulær trombosering, f.eks. i cerebrum[2].
SCD er en alvorlig sygdom med høj mortalitet, og i udviklingslande dør størstedelen af børn med SCD fortsat inden deres femte leveår [3]. Pga. forbedrede behandlingsmuligheder og infektionsprofylakse i form af penicillin og vacciner er overlevelsen blandt patienter med SCD dog forbedret betydeligt i Europa og Nordamerika i de seneste 30 år, og langt størstedelen af kvinder med SCD når nu den reproduktive alder.
FOREKOMST
På verdensplan fødes der hvert år flere end 300.000 børn med SCA. Et tal der forventes at stige til 400.000 i 2050. Hertil kommer andre former for SCD. Da personer med seglcelletræk har betydeligt øget beskyttelse over for Plasmodium falciparum-infektioner, korrelerer forekomsten af SCD med forekomsten af malaria[4]. Omkring 75% af børnene med SCA fødes i Afrika syd for Sahara [5-6].
I Nordeuropa er SCD fortsat en sjælden sygdom, men pga. øget migration har antallet af patienter været stigende i de seneste år.
SCREENING AF GRAVIDE
Sundhedsstyrelsens svangreomsorg anbefaler, at alle gravide, som stammer fra områder med høj prævalens af SCD (Tabel 1) skal screenes for hæmoglobinopatier ved første svangreundersøgelse hos en praktiserende læge.

Den gravide informeres om sygdommene og tilbydes hæmoglobinundersøgelse ved en blodprøve (hæmoglobintypning). Hvis den gravide bærer en hæmoglobinopati, er tidlig udredning af barnefaderen essentiel. Dette for at give mulighed for prænatal diagnostik og evt. senabort ved alvorlig hæmoglobinopati. Bærer begge forældre en hæmoglobinopati, skal der henvises subakut til en føtalmedicinsk afdeling mhp. tilbud om chorion villus-biopsi eller amniocentese. Det haster således med udredning, hvis der skal være mulighed for samrådsabort (inden gestationsalder 22 uger + 6 dage).
GRAVIDE MED SEGLCELLESYGDOM
Kvinder med SCD vil som regel være diagnosticeret før graviditeten og allerede blive fulgt på en hæmatologisk afdeling. Forud for planlagt graviditet anbefales det, at der foretages ekkokardiografi pga. øget risiko for pulmonal hypertension. Desuden anbefales det, at patienten ses af en øjenlæge mhp. vurdering af proliferativ retinopati, som kan forværres under en graviditet[7]. Hvis patienten har fået hyppige blodtransfusioner, skal man være opmærksom på jernophobning og alloimmunisering.
Såfremt partneren bærer en hæmoglobinopati, kan parret henvises til en fertilitetsklinik mhp. præimplantationsgenetisk diagnostik(ægsortering). Dette gælder også for forældre, der har et barn med SCD og ønsker yderligere børn.
Patienter med SCD vil oftest være i behandling med flere medikamina for at bedre sygdommen og dens følgetilstande. Hvis patienten er i behandling med hydroxycarbamid bør dette pauseres tre måneder forud for og gennem hele graviditeten[8]. Hvis der behandles med angiotensinkonverterende enzym-hæmmere eller angiotentensinreceptor ll pauseres dette ideelt set en måned inden planlagt graviditet, evt. skiftes der til et andet præparat.
SCD kan føre til øget indhold af jern i plasma pga. den kroniske hæmolyse, og jernkelerende behandling kan blive indiceret. Behandlingen er en specialistopgave, hvor infusion med deferoxaminmesilat kan anvendes under graviditeten [9]. For at mindske risikoen for infektionssygdomme gives der rutinemæssigt polyvalent pneumokokvaccine hvert femte år. Er denne ikke er givet, tilrådes der vaccine mindst én måned inden ønsket graviditet. Det samme gælder for vaccine mod Haemophilus influenzae b[10].
RISIKOFAKTORER I GRAVIDITETEN
Anæmi og seglcellesmerter er de hyppigste maternelle komplikationer, og de opstår hos omkring 50% af gravide med SCD[11]. Derudover ses en øget forekomst af sepsis, pneumoni, asymptomatisk bakteriuri, underlivsinfektioner og venøse tromboser. Der er øget risiko for intrauterin væksthæmning (IUGR), præeklampsi, gestationel hypertension, for tidlig fødsel, post partum-fødsel, abruptio og antepartum blødning[12]. Pga. risiko for graviditetskomplikationer bør gravide med SCD påbegynde forebyggende lavdosis-acetylsalisylsyrebehandling fra omkring 12. graviditetsuge [10].
HÅNDTERING AF AKUTTE SEGLCELLESMERTER UNDER GRAVIDITETEN
Seglcellesmerter (»krise«) er en medicinsk højrisikotilstand, der skal håndteres akut og tværfagligt.
Akutte smerteanfald hos patienter med SCD opstår som følge af vasookklusion, der medfører iskæmi og til tider nekrose. Smerterne er ofte lokaliseret til skelettet, hyppigst ekstremiteter, ryg, bækken og thorax. Smerterne kan være meget stærke og varer oftest 4-6 dage. Præcipiterende faktorer inkluderer, ud over graviditet, infektion, dehydratio, lav ilttension, ekstrem fysisk træning, emotionel stress, alkoholindtag, koldt vejr og medicinske sygdomme som f.eks. diabetes [13].
Smertebehandling iværksættes akut (Tabel 2), optimalt inden for 30 min. Ved indlæggelseskrævende smerter bør man påbegynde opioidbehandling. I første omgang som bolus og efterfølgende gerne som pumpebehandling. Konferer altid med en hæmatolog ved modtagelse af en patient med akutte seglcellesmerter. Ved milde til moderate smerter benyttes primært paracetamol og nonsteroide antiinflammatoriske stoffer (frem til graviditetsuge 32).

Iltsaturationen skal holdes > 94%, og der tages blodprøver samt tages fra til urin- og bloddyrkning. Desuden tages der røntgenbilleder af thorax. Dehydratio er ofte den udløsende årsag til akutte smerter, og det behandles initialt med intravenøst givet væske. Hvis den udløsende årsag konstateres, behandles denne, f.eks. med antibiotika ved tegn på infektion. Under indlæggelse behandles patienten med lavmolekylært heparin i profylaksedosis.
HÅNDTERING AF ACUTE CHEST SYNDROME UNDER GRAVIDITETEN
Acute chest syndrome (ACS) er en alvorlig komplikation og hyppig dødsårsag hos patienter med SCD. Tilstanden forekommer hos 7-20% af de gravide kvinder med SCD [9]. Syndromet er defineret ved forekomst af nytilkomne lungeinfiltrater kombineret med febrilia og/eller respiratoriske symptomer. Symptomerne kan inkludere brystsmerter, desaturation, takypnø, takykardi og febrilia[14]. Tilstanden minder om en svær pneumoni, og infektion er formentlig en vigtig ætiologisk faktor.
Differentialdiagnostisk er det svært at skelne ACS fra en lungeemboli eller pneumoni. Måling af D-dimerniveau kan ikke anvendes, da dette kan være forhøjet som følge af både graviditeten, ACS, lungeemboli og infektion.
Ved mistanke om ACS påbegyndes der akut smertebehandling samt bredspektret antibiotisk behandling og terapeutisk antikoagulation. Ved hæmoglobinniveau < 4 mmol/l gives der simple blodtransfusioner. Patienten skal behandles tværfagligt (obstetriker, hæmatolog og anæstesiolog) mhp. udskiftningstransfusioner, og hvor intensiv behandling kan blive nødvendig.
HÅNDTERING AF INFEKTIONER UNDER GRAVIDITETEN
Infektioner med kendt fokus bør som udgangspunkt behandles som hos andre gravide. Dog skal man huske, at patienter med SCD ikke har en fungerende milt (funktionelt aspleniske) og således er i særlig risiko for at få invasive infektioner med kapselbærende bakterier. Ved febrilia med ukendt fokus skal antibiotikabehandling med pneumokokdække således iværksættes akut.
SVANGREOMSORG AF GRAVIDE MED SEGLCELLESYGDOM
Svangreomsorg, svangerskabskontrol og behandling af kvinder med SCD bør ske i et tværfagligt samarbejde mellem en obstetriker med erfaring i højrisikograviditeter og en hæmatolog med særlig viden om hæmoglobinopatier. Det er nyttigt at have udarbejdet en behandlingsplan i tilfælde af akutte seglcellesmerter, herunder en transfusionsplan, individuel smerteplan samt kriterier for, hvornår patienten skal behandles på en intensivafdeling.
Transfusionbehovet er individuelt og stiger ofte som følge af en graviditet. Akut fald i hæmoglobinkoncentrationen i graviditeten kan være et tegn på forværring af den kroniske hæmolyse, men præeklampsi skal altid udelukkes [10]. Udskiftningstransfusion kan blive indiceret i akutte tilfælde, eller som profylakse til højrisikopatienter. Dette skal altid ske i samarbejde med en hæmatologisk afdeling og blodbanken.
Den gravide bør ses til kontrol hos en obstetriker én gang månedligt i tredje trimester med samtidig tilvækstskanning af fosteret [11].
Der skal screenes for alloimmunisering, hiv samt hepatitis B og C. Jernmangel ses normalt ikke, da kronisk hæmolyse og hyppige blodtransfusioner resulterer i jernophobning. Jerntilskud anbefales derfor ikke med mindre jernmangel er dokumenteret i form af lavt ferritinniveau[15]. Folinsyretilskud bør tages i højere dosis end normalt, 5 mg/dag [8]. Man skal være opmærksom på hyperemesis for at undgå dehydrering, da dette kan medvirke til udviklingen af akutte seglcellesmerter[16].
FØDSEL
SCD kontraindicerer ikke vaginal fødsel, og sectio foretages kun på obstetrisk indikation. Nekrose af caput femoris ses relativt ofte hos kvinder med SCD, og alloplastik kan reducere mulige fødestillinger. Der bør køres kontinuerlig kardiotokografi pga. øget risiko for placentasygdom [12]. Den fødende holdes varm og anbefales at hvile, når det er muligt. Ligeledes bør der foretages intermitterende pulsoxymetri af den fødende, da iltsaturationen skal holdes > 94% under hele fødslen. Der bør være lav tærskel for intravenøs indgift af væske, og man skal være særligt opmærksom på dehydrering ved langvarige forløb.
Smertebehandling med epiduralkateter anbefales, da smerter under en fødsel kan præcipitere en krise [10]. Hvis der planlægges elektivt sectio, skal der på forhånd bestilles blod med udvidet fænotype, da det kan være svært at skaffe passende blod, og samtidig skal alloimmunisering af mater forebygges [17]. Spinalanæstesi anbefales.
POST PARTUM
Man skal være proaktiv ift. smertestillende midler samt motivere kvinden til mobilisering og væskeindtag. Ved tegn til infektion påbegyndes antibiotisk behandling. Hvis kvinden skal genoptage hydroxycarbamidbehandlingen frarådes amning, ellers ikke [8]. Støttestrømper og lavmolekylært heparin i profylaksedosis anbefales i ti dage efter vaginal forløsning hos en patient, der ikke har haft komplikationer, og op til seks uger ved mere komplicerede forløb [10].
Barnet screenes for hæmoglobinopatier.
KONKLUSION
Pga. øget global migration ses en stigende incidens af gravide kvinder med SCD i Danmark. SCD er under graviditeten associeret med komplikationer for både mor og barn, herunder perinatal mortalitet, præterm fødsel, IUGR, vasookklusive kriser og tromboser. For at sikre disse kvinder den bedst mulige behandling, er det vigtigt, at læger og andet sundhedspersonale er opmærksomme på de særlige problemstillinger og har sufficient viden om, hvordan de skal håndteres.
KORRESPONDANCE: Thomas Christensen. E-mail: thomasc87@hotmail.com
ANTAGET: 1. september 2020
PUBLICERET PÅ UGESKRIFTET.DK: 19. oktober 2020
INTERESSEKONFLIKTER: ingen. Forfatternes ICMJE-formularer er tilgængelige sammen med artiklen på Ugeskriftet.dk
LITTERATUR: Findes i artiklen publiceret på Ugeskriftet.dk
Litteratur
Pauling L, Itano HA, Singer SJ et al. Sickle cell anaemia a molecular disease. Science 1949;110:543-8.
Piel FB, Steinberg MH, Rees DC. Sickle cell disease. N Engl J Med 2017;376:1561-73.
Williams TN. Sickle cell disease in Sub-Saharan Africa. Hematol Oncol Clin North Am 2016;30:343‐58.
Uyoga S, Macharia AW, Ndila CM et al. The indirect health effects of malaria estimated from health advantages of the sickle cell trait. Nat Commun 2019;10:856.
Piel FB, Hay SI, Gupta S et al. Global burden of sickle cell anaemia in children under five, 2010-2050: modelling based on demographics, excess mortality, and interventions. PLoS Med 2013;10:e1001484.
Diallo D, Tchernia G. Sickle cell disease in Africa. Curr Opin Hematol 2002;9:111-6.
Clarkson JG. The ocular manifestations of sickle-cell disease: a prevalence and natural history study. Trans Am Ophthalmol Soc 1992;90:481‐504.
Pre-conceptual advice. I: Standards for the clinical care of adults with sickle cell disease in the UK. 2nd ed. Sickle Cell Society, 2018:171.
Singer ST, Vichinsky EP. Deferoxamine treatment during pregnancy: is it harmful? Am J Hematol 1999;60:24‐6.
RCOG. Management of sickle cell disease in pregnancy. https://www.rcog.org.uk/globalassets/documents/guidelines/gtg_61.pdf (1. jun 2020).
Adams S. Caring for the pregnant woman with sickle cell crisis. Prof Care Mother Child 1996;6:34‐6.
Villers MS, Jamison MG, De Castro LM et al. Morbidity associated with sickle cell disease in pregnancy. Am J Obstet Gynecol 2008;199:125.e1.
Firth PG, Head CA. Sickle cell disease and anesthesia. Anesthesiology 2004;101:766-85.
Ballas SK, Lieff S, Benjamin LJ et al. Definitions of the phenotypic manifestations of sickle cell disease. Am J Hematol 2010;85:6‐13.
Abudu OO, Macaulay K, Oluboyede OA. Serial evaluation of iron stores in pregnant Nigerians with hemoglobin SS or SC. J Natl Med Assoc 1990;82:41.
Hassell K. Pregnancy and sickle cell disease. Hematol Oncol Clin North Am 2005;19:903.
Raba M. Selecting red blood cell units to perform RBCX in patients with sickle cell disease. Transfus Apher Sci 2019;58:142-6.
Thomas Christensen, Amina Nardo-Marino, Andreas Glenthøj & Morten Beck Sørensen
Ugeskr Læger 2020;182:V06200420
Sickle cell disease (SCD) is the most common severe hereditary disease worldwide. SCD during pregnancy is associated with increased incidence of perinatal mortality, premature labour, foetal growth restriction, and acute painful crises. Global migration has contributed to a greater geographical spread of individuals with hereditary haemoglobinopathies. This has led to an increased incidence of pregnant women with SCD in Denmark. In this review, we descibe the aetiology, assessment, antenatal care and treatment of pregnant women with SCD.